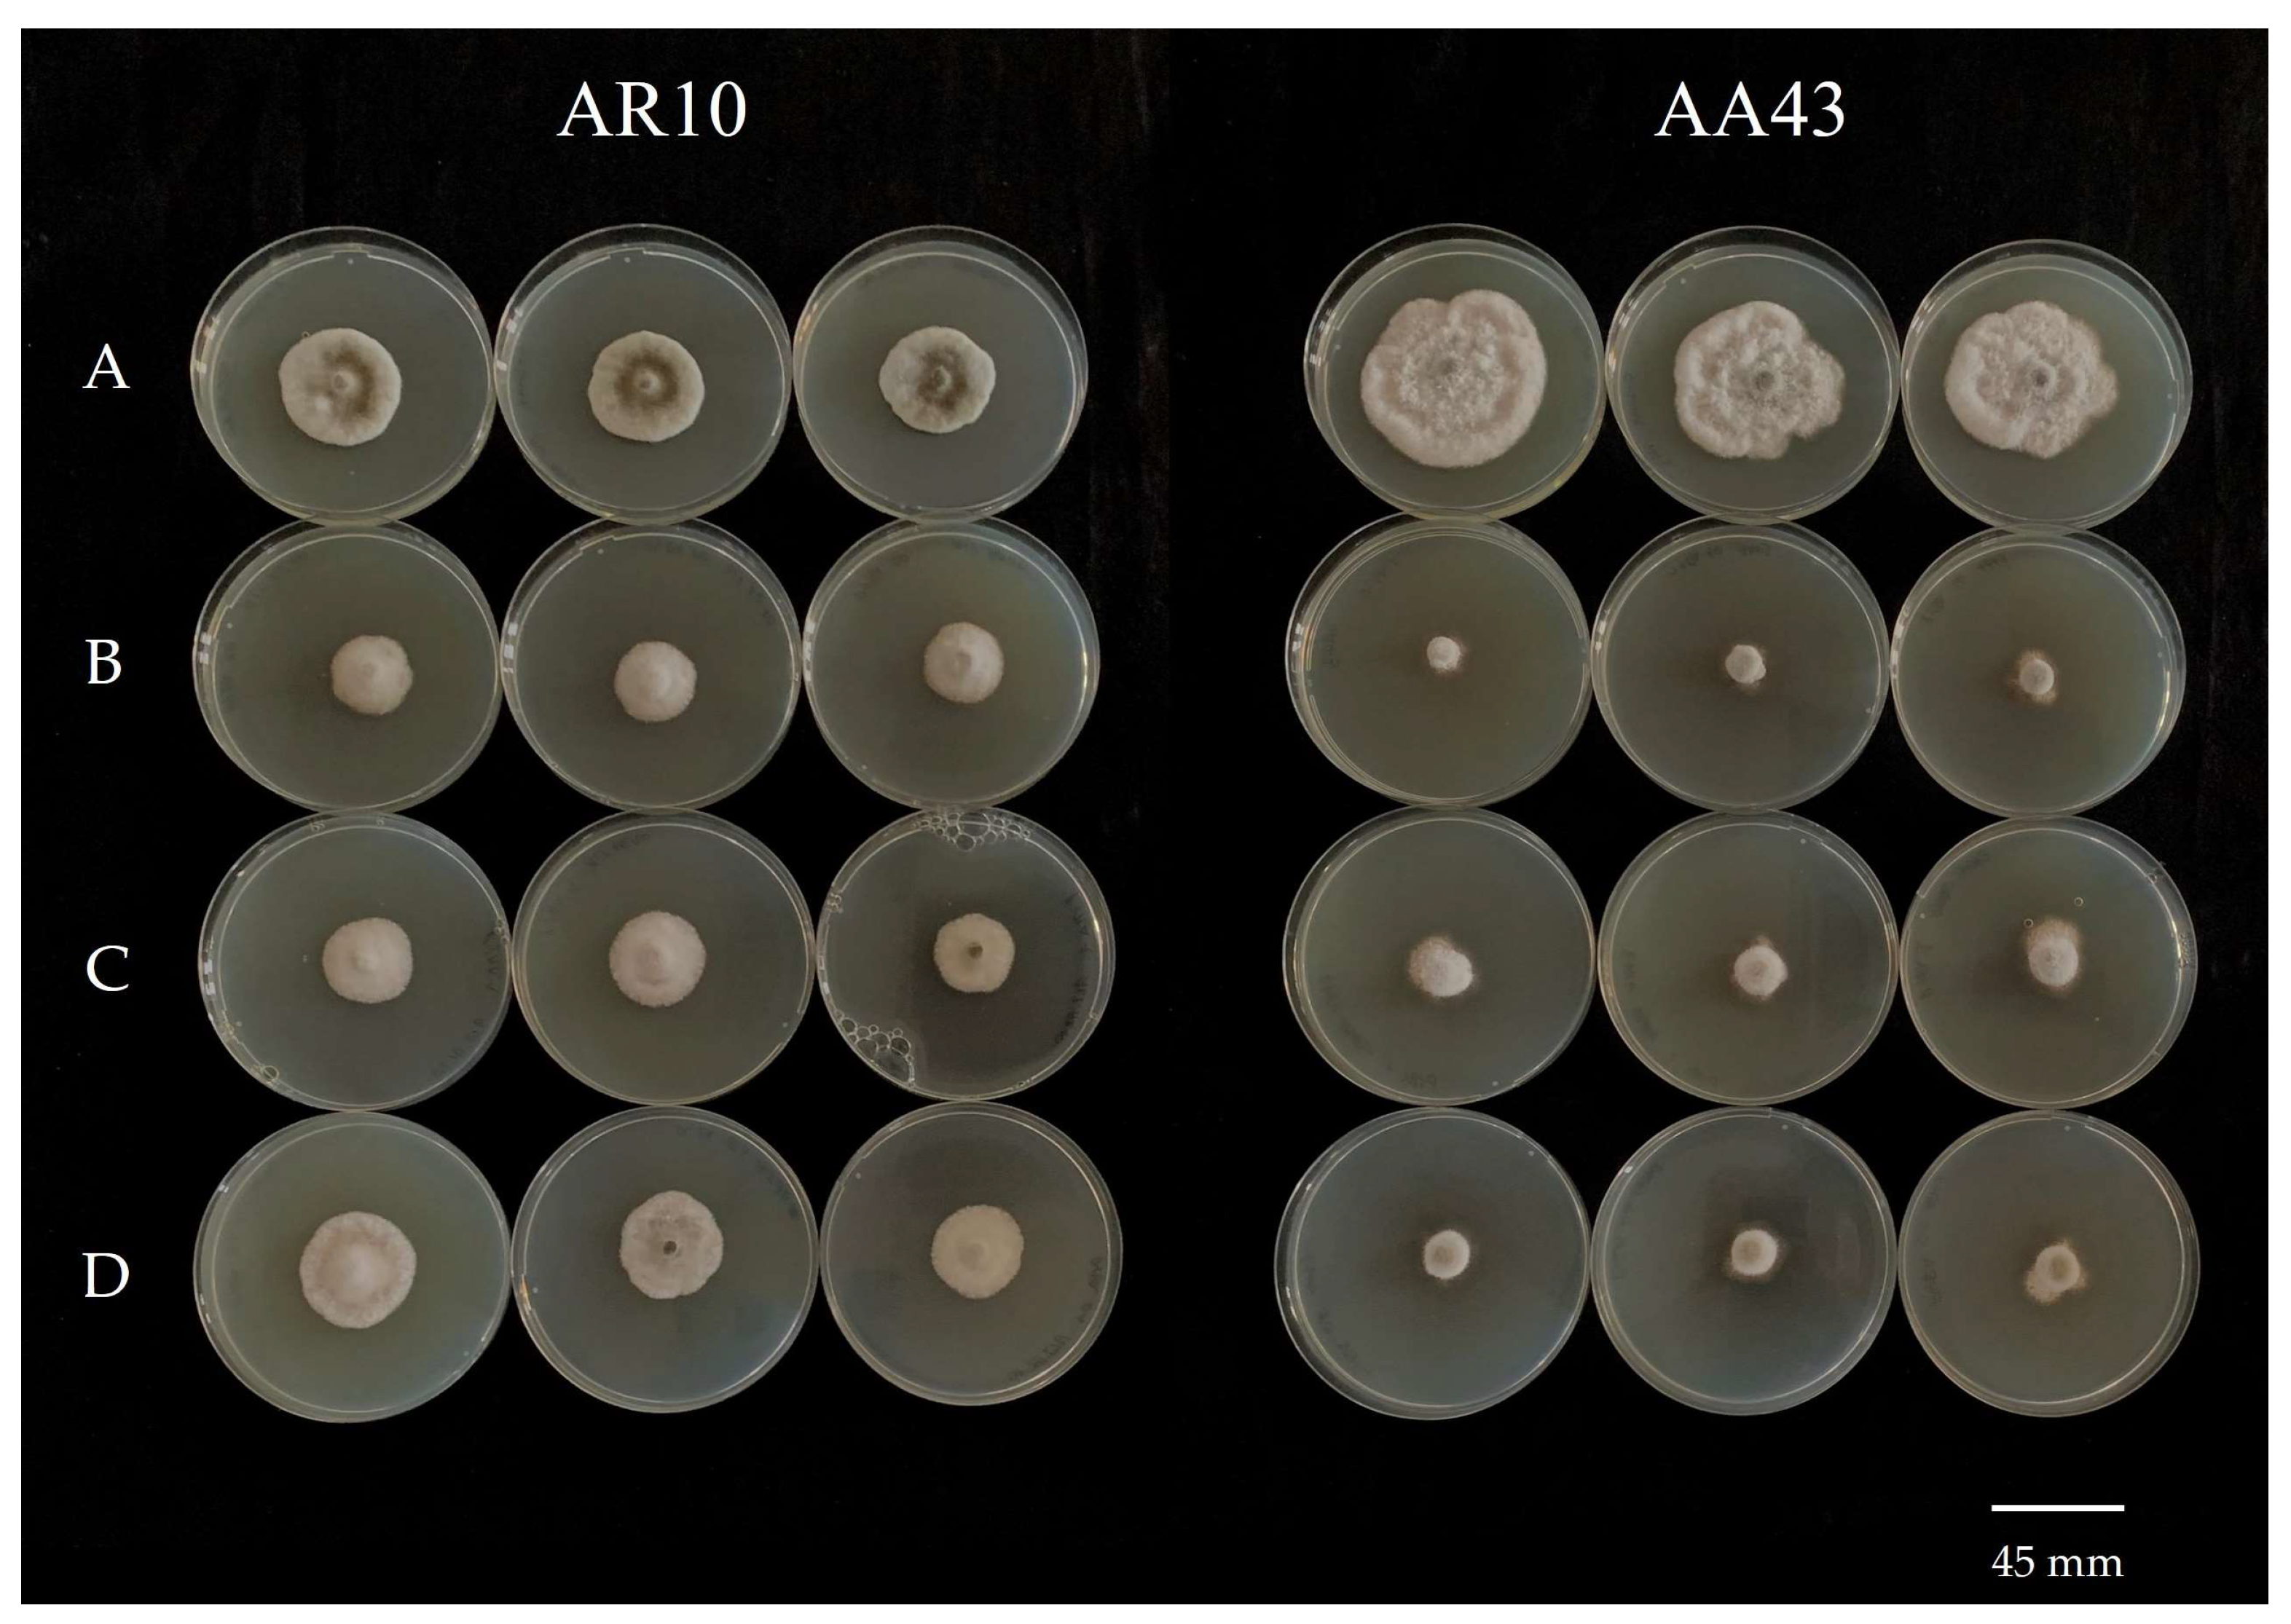
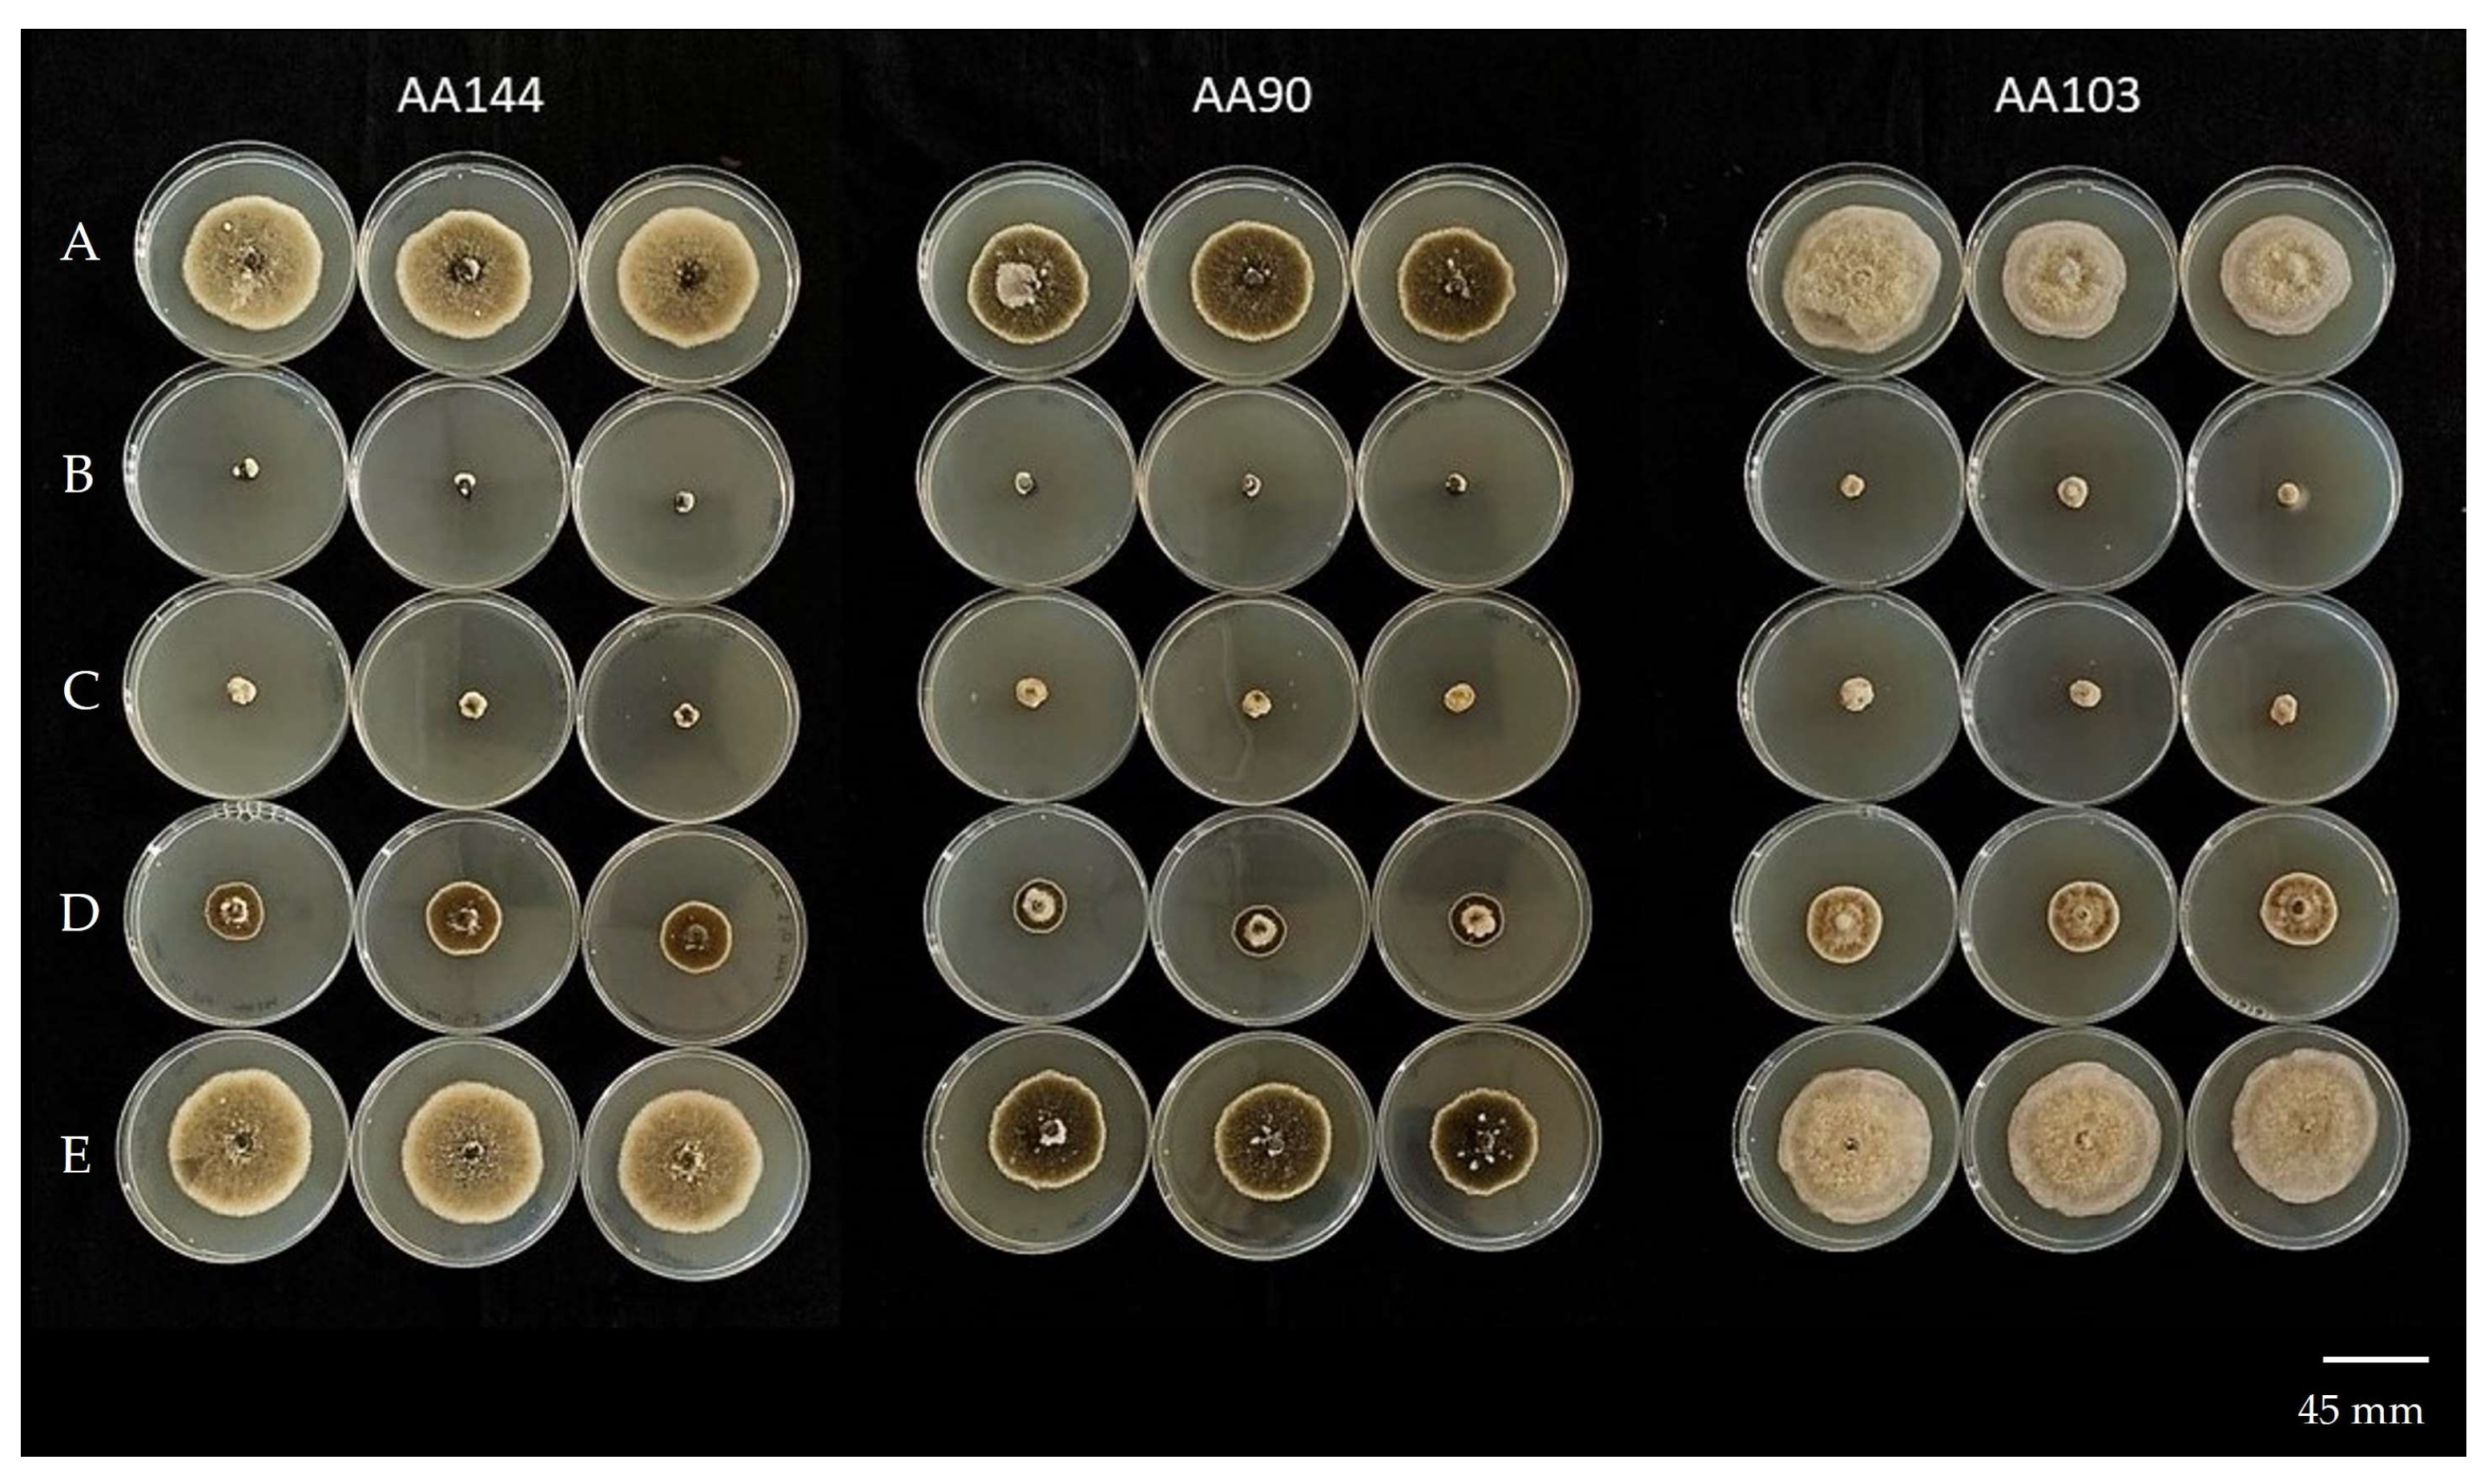

Sensitivity Profile to Pyraclostrobin and Fludioxonil of Alternaria alternata from Citrus in Italy
Abstract
1. Introduction
2. Materials and Methods
2.1. Fungal Isolates and Fungicides
2.2. DNA Extraction, PCR Amplification, and Sequencing
2.3. Phylogenetic Analyses
2.4. In Vitro Sensitivity of A. alternata to Fungicides
2.4.1. Mycelial Growth Assay
2.4.2. Spore Germination Assay
2.5. Analysis of the Cyt b Gene Region of A. alternata Isolates
2.6. Detached Leaf Bioassay
2.7. Fitness Assessment
2.7.1. Mycelial Growth
2.7.2. Spore Production Rate
2.8. Data Analyses
3. Results
3.1. Phylogenetic Analyses
3.2. In Vitro Sensitivity of A. alternata to Pyraclostrobin
| EC50 Range (μg mL−1) for Mycelial Growth Reduction | ||||
|---|---|---|---|---|
| <0.01 | 0.01–1 | 1–10 | 10–100 | >100 |
| - | AA1, AA36, AA43, AA102, AA103, MN3 | AA16, AA24, AA63, AA64, AA74, AA92, AA93, AA94, AA108, AA118, MN1, MN7, AR2, AR6, AR7, AR8, AR11 | AA2, AA12, AA71, AA72, AA88, AA89, AA90, AA100, AA119, AA144, AR1, AR3, AR9 | AA14, AA25, AA27, AA28, AA62, AA73, AA99, AA107, AA143, MN4, MN5, AR10 |
| EC50 Range (μg mL−1) for Spore Germination Inhibition | ||||
| <0.01 | 0.01–1 | 1–10 | 10–100 | >100 |
| AA1, AA14, AA25, AA28, AA36, AA64, AA71, AA72, AA89, AA90, AA103, AA107, AA108, AA118, AA119, AA143, MN1, MN3, | AA12, AA16, AA62, AA63, AA73, AA88, AA102, AR2, AR9, AR10 | AA99 | AA2, AA27, AA144, MN5 | - |

3.3. In Vitro Baseline Sensitivity of A. alternata to Fludioxonil
| Fludioxonil EC50 Range (μg mL−1) | |||
|---|---|---|---|
| 0–0.25 | 0.26–0.50 | 0.51–0.75 | 0.76–0.99 |
| AA1, AA12, AA14, AA16, AA24, AA36, AA43, AA64, AA71, AA72, AA73, AA74, AA88, AA90, AA92, AA94, AA99, AA102, AA103, AA107, AA108, AA118, AA143, AA144, MN1, MN7, AR1, AR2, AR3, AR6, AR10 | AA2, AA25, AA28, AA62, AA63, AA89, AA93, AA100, AA119, MN3, MN4, MN5, AR7, AR8, AR9, | - | AA27, AR11 |

3.4. Analysis of the Cyt b Gene Region of A. alternata Isolates
3.5. In Vivo Fungicide Effects in Reducing Infections of A. alternata at Different Pyraclostrobin Sensitivity
| Isolates | Treatment | DI (%) y | DI (va) y | SS (%) y | SS (va) y |
|---|---|---|---|---|---|
| Sensitive | |||||
| A. alternata AA1 | Control x | 100.0 ± 0.0 a | 90.0 | 60.7 ± 4.8 a | 51.3 |
| Pyraclostrobin | 20.0 ± 10.3 b | 21.9 | 0.9 ± 0.5 b | 4.2 | |
| Reduction (%) | 80.0 | 98.6 | |||
| ** | *** | ||||
| A. alternata AA28 | Control x | 100.0 ± 0.0 a | 90.0 | 64.3 ± 2.2 a | 53.3 |
| Pyraclostrobin | 16.7 ± 7.9 b | 19.9 | 3.9 ± 1.8 b | 9.2 | |
| Reduction (%) | 83.3 | 94.0 | |||
| ** | *** | ||||
| A. alternata AA62 | Control x | 96.7 ± 3.0 a | 83.9 | 43.8 a | 41.4 |
| Pyraclostrobin | 3.3 ± 2.9 b | 6.1 | 0.28 b | 1.75 | |
| Reduction (%) | 96.6 | 99.4 | |||
| *** | *** | ||||
| A. alternata AA90 | Control x | 100.0 ± 0.0 a | 90.0 | 44.6 ± 8.4 a | 41.8 |
| Pyraclostrobin | 20.0 ± 8.9 b | 22.1 | 4.2 ± 2.1 b | 9.6 | |
| Reduction (%) | 80.0 | 90.5 | |||
| ** | *** | ||||
| Reduced sensitivity | |||||
| A. alternata AA2 | Control x | 96.7 ± 3.0 a | 83.9 | 26.6 ± 4.9 a | 30.8 |
| Pyraclostrobin | 50.0 ± 13.7 b | 44.7 | 9.4 ± 2.1 b | 17.6 | |
| Reduction (%) | 48.3 | 64.7 | |||
| * | * | ||||
| A. alternata AA27 | Control x | 100.0 ± 0.0 a | 90.0 | 70.0 ± 0.8 a | 56.8 |
| Pyraclostrobin | 66.7 ± 7.9 b | 55.1 | 15.6 ± 1.2 b | 23.2 | |
| Reduction (%) | 33.3 | 77.7 | |||
| * | ** |

3.6. Fitness Assessment
4. Discussion
Author Contributions
Funding
Data Availability Statement
Conflicts of Interest
References
- Elena, K. Alternaria brown spot of Minneola in Greece; evaluation of citrus species susceptibility. Eur. J. Plant Pathol. 2006, 115, 259–262. [Google Scholar] [CrossRef]
- Bella, C.; Guarino, R.; La Rosa, A. Severe infections of Alternaria spp. on a mandarin hybrid. J. Plant Pathol. 2001, 83, 231. [Google Scholar]
- Vicent, A.; Armengol, J.; Sales, R.; García-Jiménez, J. First report of Alternaria brown spot of citrus in Spain. Plant Dis. 2000, 84, 1044. [Google Scholar] [CrossRef] [PubMed]
- Timmer, L.W.; Peever, T.L.; Solel, Z.; Akimitsu, K. Alternaria disease of citrus-novel pathosystems. Phytopathol. Mediterr. 2003, 42, 99–112. [Google Scholar] [CrossRef]
- Aiello, D.; Guarnaccia, V.; Azzaro, A.; Polizzi, G. Alternaria brown spot on new clones of sweet orange and lemon in Italy. Phytopathol. Mediterr. 2020, 59, 131–145. [Google Scholar] [CrossRef]
- Vitale, A.; Aiello, D.; Azzaro, A.; Guarnaccia, V.; Polizzi, G. An eleven-year survey on field disease susceptibility of citrus accessions to Colletotrichum and Alternaria species. Agriculture 2021, 11, 536. [Google Scholar] [CrossRef]
- European Commission. 2020. Available online: https://eur-lex.europa.eu/legal-content/EN/TXT/PDF/?uri=CELEX:32020R2087&rid=6 (accessed on 26 January 2024).
- Fungicide Resistance Action Committee (FRAC). 2023. Available online: https://www.frac.info/docs/default-source/publications/frac-code-list/frac-code-list-2023---final.pdf?sfvrsn=78bc4e9a_2 (accessed on 26 January 2024).
- Fernández-Ortuño, D.; Torés, J.A.; De Vicente, A.; Pérez-García, A. Mechanisms of resistance to QoI fungicides in phytopathogenic fungi. Int. Microbiol. 2008, 11, 1. [Google Scholar]
- Fernández-Ortuño, D.; Tores, J.A.; Pérez-García, A. The QoI fungicides, the rise and fall of a successful class of agricultural fungicides. In Fungicides; Carisse, O., Ed.; InTech: London, UK, 2010; pp. 203–220. [Google Scholar] [CrossRef]
- Vega, B.; Liberti, D.; Harmon, P.F.; Dewdney, M.M. A rapid resazurin-based microtiter assay to evaluate QoI sensitivity for Alternaria alternata isolates and their molecular characterization. Plant Dis. 2012, 96, 1262–1270. [Google Scholar] [CrossRef] [PubMed]
- Sierotzki, H.; Wullschleger, J.; Gisi, U. Point-mutation in cytochrome b gene conferring resistance to strobilurin fungicides in Erysiphe graminis f. sp. tritici field isolates. Pestic. Biochem. Physiol. 2000, 68, 107–112. [Google Scholar] [CrossRef]
- Sierotzki, H.; Parisi, S.; Steinfeld, U.; Tenzer, I.; Poirey, S.; Gisi, U. Mode of resistance to respiration inhibitors at the cytochrome bc1 enzyme complex of Mycosphaerella fijiensis field isolates. Pest Manag. Sci. 2000, 56, 833–841. [Google Scholar] [CrossRef]
- Goes, A.D.; Montes de Oca, A.G.; Reis, R.F. Ocurrencia de la mancha de Alternaria en mandarina Dancy en el estado de Rio de Janeiro. Fitopatol. Bras. 2001, 26, 386. [Google Scholar]
- Sierotzki, H.; Frey, R.; Wullschleger, J.; Palermo, S.; Karlin, S.; Godwin, J.; Gisi, U. Cytochrome b gene sequence and structure of Pyrenophora teres and P. tritici-repentis and implications for QoI resistance. Pest Manag. Sci. 2007, 63, 225–233. [Google Scholar] [CrossRef]
- Bartlett, D.W.; Clough, J.M.; Godwin, J.R.; Hall, A.A.; Hamer, M.; Parr-Dobrzanski, B. Review: The strobilurin fungicides. Pest Manag. Sci. 2002, 58, 649–662. [Google Scholar] [CrossRef] [PubMed]
- Leadbeater, A. Resistance risk to QoI fungicides and anti-resistance strategies. In Fungicide Resistance in Crop Protection: Risk and Management; Tarlochan, S., Ed.; CABI: Wallingford, UK, 2012; pp. 141–154. [Google Scholar] [CrossRef]
- Dewdney, M.M.; Vega, B.; Peres, N.A.; Graham, J.H. Fungicide Resistance in Citrus Pathogens. In Fungicide Resistance in North America; Stevenson, K.L., McGrath, M.T., Wyenandt, C.A., Eds.; The American Phytopathological Society: St. Paul, MN, USA, 2019; pp. 233–250. [Google Scholar] [CrossRef]
- Chitolina, G.R.; Silva-Junior, G.J.; Feichtenberger, E.; Pereira, E.G.; Amorim, L. Distribution of Alternaria alternata isolates with resistance to quinone outside inhibitor (QoI) fungicides in Brazilian orchards of tangerines and their hybrids. Crop Prot. 2021, 141, 105493. [Google Scholar] [CrossRef]
- Dube, J.P.; Truter, M.; van der Waals, J.E. first report of resistance to QoI fungicides in Alternaria alternata isolates from potato in South Africa. Plant Dis. 2014, 98, 1431. [Google Scholar] [CrossRef] [PubMed]
- Avenot, H.F.; Michailides, T.J. Detection of isolates of Alternaria alternata with multiple-resistance to fludioxonil, cyprodinil, boscalid and pyraclostrobin in California pistachio orchards. Crop Prot. 2015, 78, 214–221. [Google Scholar] [CrossRef]
- Chitolina, G.M.; Silva-Junior, G.J.; Feichtenberger, E.; Pereira, R.G.; Amorim, L. First report on quinone outside inhibitor resistance of Alternaria alternata causing alternaria brown spot in tangerines in São Paulo, Brazil. Plant Health Prog. 2019, 20, 94. [Google Scholar] [CrossRef]
- Ministero Della Salute. 2021. Available online: https://www.salute.gov.it/portale/temi/documenti/fitosanitari/2021/28_07_2021_est_impiego_in_deroga_GEOXE.pdf (accessed on 3 November 2022).
- Ministero Della Salute. 2022. Available online: https://www.salute.gov.it/portale/temi/documenti/fitosanitari/2022/GEOXE.pdf (accessed on 3 November 2022).
- Ministero Della Salute. 2023. Available online: https://www.salute.gov.it/portale/temi/documenti/fitosanitari/2023/13_09_2023_GEOXE.pdf (accessed on 11 January 2024).
- Kilani, J.; Fillinger, S. Phenylpyrroles: 30 years, two molecules and (nearly) no resistance. Front. Microbiol. 2016, 16, 7. [Google Scholar] [CrossRef]
- Bersching, K.; Jacob, S. The molecular mechanism of fludioxonil action is different to osmotic stress sensing. J. Fungi 2021, 7, 393. [Google Scholar] [CrossRef]
- White, T.J.; Bruns, T.D.; Lee, S.B.; Taylor, J.W. Amplification and direct sequencing of fungal ribosomal RNA genes for phylogenetics. In PCR Protocols—A Guide to Methods and Applications; Innis, M.A., Gelfand, D.H., Sninsky, J.J., White, T.J., Eds.; Academic Press: New York, NY, USA, 1990; pp. 15–322. [Google Scholar]
- Berbee, M.L.; Pirseyedi, M.; Hubbard, S. Cochliobolus phylogenetics and the origin of known, highly virulent pathogens, inferred from ITS and glyceraldehyde-3-phosphate dehydrogenase gene sequences. Mycologia 1999, 91, 964–977. [Google Scholar] [CrossRef]
- Carbone, I.; Kohn, L.M. A method for designing primer sets for speciation studies in filamentous ascomycetes. Mycologia 1999, 91, 553–556. [Google Scholar] [CrossRef]
- Kumar, S.; Stecher, G.; Li, M.; Knyaz, C.; Tamura, K. MEGA X: Molecular evolutionary genetics analysis across computing platforms. Mol. Biol. Evol. 2018, 35, 1547–1549. [Google Scholar] [CrossRef]
- Hall, T.A. BioEdit: A User-Friendly Biological Sequence Alignment Editor and Analysis Program for Windows 95/98/NT. Nucleic Acids Symp. Ser. 1999, 41, 95–98. [Google Scholar]
- Smith, S.A.; Dunn, C.W. Phyutility: A phyloinformatics tool for trees, alignments and molecular data. Bioinformatics 2008, 24, 715–716. [Google Scholar] [PubMed]
- Stamatakis, E. RAxML-VI-HPC: Maximum likelihood-based phylogenetic analyses with thousands of taxa and mixed models. Bioinformatics 2006, 22, 2688–2690. [Google Scholar] [CrossRef]
- Silvestro, D.; Michalak, I. RaxmlGUI: A graphical front-end for RAxML. Org. Divers. Evol. 2012, 12, 335–337. [Google Scholar] [CrossRef]
- Swofford, D.L. PAUP*: Phylogenetic Analysis Using Parsimony (*and Other Methods) Version 4; Sinauer Associates: Sunderland, MA, USA, 2002. [Google Scholar] [CrossRef]
- Mondal, S.N.; Bhatia, A.; Shilts, T.; Timmer, L.W. Baseline sensitivities of fungal pathogens of fruit and foliage of citrus to azoxystrobin, pyraclostrobin, and fenbuconazole. Plant Dis. 2015, 89, 1186–1194. [Google Scholar] [CrossRef]
- Fungicide Resistance Action Committee (FRAC). FRAC Monitoring Method. 2006. Available online: https://www.frac.info/docs/default-source/monitoring-methods/approved-methods/alteso-monitoring-method-syngenta-2006-v1.pdf?sfvrsn=619a419a_4 (accessed on 26 January 2024).
- Camiletti, B.X.; Lichtemberg, P.S.; Paredes, J.A.; Carraro, T.A.; Velascos, J.; Michailides, T.J. Characterization, pathogenicity, and fungicide sensitivity of Alternaria isolates associated with preharvest fruit drop in California citrus. Fungal Biol. 2022, 126, 277–289. [Google Scholar] [CrossRef]
- Grasso, V.; Palermo, S.; Sierotzki, H.; Garibaldi, A.; Gisi, U. Cytochrome b gene structure and consequences for resistance to Qo inhibitor fungicides in plant pathogens. Pest Manag. Sci. 2006, 62, 465–472. [Google Scholar] [CrossRef]
- Duba, A.; Goriewa, K.; Wachowska, U.; Wiwart, M. Alternaria alternata (Fr.) Keissl with mutation G143A in the cyt b gene is the source of a difficult-to-control allergen. Environ. Sci. Pollut. Res. 2018, 25, 469–478. [Google Scholar] [CrossRef]
- Malandrakis, A.A.; Apostolidou, Z.A.; Louka, D.; Markoglou, A.; Flouri, F. Biological and molecular characterization of field isolates of Alternaria alternata with single or double resistance to respiratory complex II and III inhibitors. Eur. J. Plant Pathol. 2018, 152, 199–211. [Google Scholar] [CrossRef]
- Nottensteiner, M.; Absmeier, C.; Zellner, M. QoI fungicide resistance mutations in Alternaria solani and Alternaria alternata are fully established in potato growing areas in bavaria and dual resistance against SDHI fungicides is upcoming. Gesunde Pflanz. 2019, 71, 155–164. [Google Scholar] [CrossRef]
- Ma, Z.; Michailides, T.J. A real-time PCR assay for the detection of azoxystrobin-resistant Alternaria populations from pistachio orchards in California. Crop. Prot. 2004, 23, 1259–1263. [Google Scholar] [CrossRef]
- Luo, Y.; Ma, Z.; Reyes, H.C.; Morgan, D.P.; Michailides, T.J. Using real-time PCR to survey frequency of azoxystrobin-resistant allele G143A in Alternaria populations from almond and pistachio orchards in California. Pestic. Biochem. Phys. 2007, 88, 328–336. [Google Scholar] [CrossRef]
- Schneider, C.A.; Rasband, W.S.; Eliceiri, K.W. NIH image to ImageJ: 25 years of image analysis. Nat. Methods 2012, 9, 671–675. [Google Scholar] [CrossRef] [PubMed]
- Karaoglanidis, G.S.; Luo, Y.; Michailides, T.J. Competitive ability and fitness of Alternaria alternata isolates resistant to QoI fungicides. Plant. Dis. 2011, 95, 178–182. [Google Scholar] [CrossRef] [PubMed]
- Panebianco, A.; Castello, I.; Cirvilleri, G.; Perrone, G.; Epifani, F.; Ferrara, M.; Polizzi, G.; Walters, D.R.; Vitale, A. Detection of Botrytis cinerea field isolates with multiple fungicide resistance from table grape in Sicily. Crop Prot. 2015, 77, 65–73. [Google Scholar] [CrossRef]
- Vitale, A.; Panebianco, A.; Polizzi, G. Baseline sensitivity and efficacy of fluopyram in Botrytis cinerea from table grape in Italy. Ann. Appl. Biol. 2016, 169, 36–45. [Google Scholar] [CrossRef]
- Fragalà, F.; Castello, I.; Puglisi, I.; Padoan, E.; Baglieri, A.; Montoneri, E.; Vitale, A. New insights into municipal biowaste derived products as promoters of seed germination and potential antifungal compounds for sustainable agriculture. Chem. Biol. Technol. Agric. 2022, 9, 69. [Google Scholar] [CrossRef]
- Ma, Z.; Felts, D.; Michailides, T.J. Resistance to azoxystrobin in Alternaria isolates from pistachio in California. Pestic. Biochem. Physiol. 2003, 77, 6–74. [Google Scholar] [CrossRef]
- ISTAT, Istituto Nazionale di Statistica. 2021. Available online: http://dati.istat.it/ (accessed on 11 January 2023).
- Avenot, H.; Morgan, D.P.; Michailides, T.J. Resistance to pyraclostrobin, boscalid and multiple resistance to Pristine® (pyraclostrobin & boscalid) fungicide in Alternaria alternata causing alternaria late blight of pistachios in California. Plant Pathol. 2008, 57, 135–140. [Google Scholar] [CrossRef]
- Ishii, H.; Fraaije, B.A.; Sugiyama, T.; Noguchi, K.; Nishimura, K.; Takeda, T.; Amano, T.; Hollomon, D.W. Occurrence and molecular characterization of strobilurin resistance in cucumber powdery mildew and downy mildew. Phytopathology 2001, 91, 1166–1171. [Google Scholar] [CrossRef] [PubMed]
- Baroffio, C.A.; Siegfried, W.; Hilber, U.W. Long-term monitoring for resistance of Botryotinia fuckeliana to anilinopyrimidine, phenylpyrrole and hydroxyanilide fungicides in Switzerland. Plant Dis. 2003, 87, 662–666. [Google Scholar] [CrossRef] [PubMed][Green Version]
- Gisi, U.; Sierotzki, H.; Cook, A.; McCaffery, A. Mechanisms influencing the evolution of resistance to Qo inhibitor fungicides. Pest Manag. Sci. 2002, 58, 859–867. [Google Scholar] [CrossRef] [PubMed]
- Fan, Z.; Yang, J.H.; Fan, F.; Luo, C.X.; Schnabel, G. Fitness and competitive ability of Alternaria alternata field isolates with resistance to SDHI, QoI, and MBC fungicides. Plant Dis. 2015, 99, 1744–1750. [Google Scholar] [CrossRef]
- Pasche, J.S.; Wharam, C.M.; Gudmestad, N.C. Shift in sensitivity of Alternaria solani in response to QoI fungicides. Plant Dis. 2004, 88, 181–187. [Google Scholar] [CrossRef]
- Miao, J.; Zhao, G.; Wang, B.; Du, Y.; Li, Z.; Gao, X.; Zhang, C.; Liu, X. Three point-mutations in cytochrome b confer resistance to trifloxystrobin in Magnaporthe oryzae. Pest Manag. 2020, 76, 4258–4267. [Google Scholar] [CrossRef]
- Li, C.; Wang, K.; Zhang, H.; Yang, D.; Deng, Y.; Wang, Y.; Qi, Z. Development of a LAMP method for detecting F129L mutant in azoxystrobin-resistant Pyricularia oryzae. Fungal Biol. 2022, 126, 47–53. [Google Scholar] [CrossRef]
- Schoustra, S.E.; Slakhorst, M.; Debets, A.J.M.; Hoekstra, R.F. Comparing artificial and natural selection in rate of adaptation to genetic stress in Aspergillus nidulans. J. Evol. Biol. 2005, 18, 771–778. [Google Scholar] [CrossRef]
- Jeger, M.J.; Wijngaarden, P.J.; Hoekstra, R.F. Adaptation to the cost of resistance in a haploid clonally reproducing organism: The role of mutation, migration, and selection. J. Theor. Biol. 2008, 252, 621–632. [Google Scholar] [CrossRef]
- Wang, F.; Saito, S.; Michailides, T.J.; Xiao, C.L. Fungicide resistance in Alternaria alternata from blueberry in California and its impact on control of Alternaria rot. Plant Dis. 2022, 106, 1446–1453. [Google Scholar] [CrossRef] [PubMed]
- Wang, F.; Seiya, S.; Xiao, C.L. Fungicide resistance of Alternaria alternata and A. arborescens isolates from mandarin fruit and its influence on control of postharvest Alternaria rot. Plant Dis. 2023, 107, 1538–1543. [Google Scholar] [CrossRef] [PubMed]
- Budde-Rodriguez, S.; Pasche, J.S.; Mallik, I.; Gudmestad, N.C. Sensitivity of Alternaria spp. from potato to pyrimethanil, cyprodinil, and fludioxonil. Crop Prot. 2022, 152, 105855. [Google Scholar] [CrossRef]

| Species Name | Strains a | Status b | Host | Country | GenBank Accessions c | ||
|---|---|---|---|---|---|---|---|
| ITS | gapdh | tef1 | |||||
| Alternaria alstroemeriae | E.G.S. 50.116 | R | Alstroemeria sp. | USA | KP124296 | KP124153 | KP125071 |
| A. alstroemeriae | MAFF 1219 | T | Alstroemeria sp. | Australia | KP124297 | KP124154 | KP125072 |
| A. alternantherae | CBS 124392 | Solanum melongena | China | KC584179 | KC584096 | KC584633 | |
| A. alternata | CBS 106.24 | T | Malus sylvestris | USA | KP124298 | KP124155 | KP125073 |
| A. alternata | CBS 102595 | T | Citrus jambhiri | USA | FJ266476 | AY562411 | KC584666 |
| A. alternata | CBS 103.33 | T | Soil | Egypt | KP124302 | KP124159 | KP125077 |
| A. alternata | CBS 102.47 | T | Citrus sinensis | USA | KP124304 | KP124161 | KP125080 |
| A. alternata | CBS 479.90 | T | Citrus unshiu | Japan | KP124319 | KP124174 | KP125095 |
| A. alternata | CBS 102596 | T | Citrus jambhiri | USA | KP124328 | KP124183 | KP125104 |
| A. alternata | CBS 102598 | T | Minneola tangelo | USA | KP124329 | KP124184 | KP125105 |
| A. alternata | CBS 102600 | T | Citrus reticulata | USA | KP124331 | KP124186 | KP125107 |
| A. alternata | CBS 102599 | T | Minneola tangelo | USA | KP124330 | KP124185 | KP125106 |
| A. alternata | CBS 102602 | T | Minneola tangelo | Turkey | KP124332 | KP124187 | KP125108 |
| A. alternata | CBS 102603 | T | Minneola tangelo | Israel | KP124333 | KP124188 | KP125109 |
| A. alternata | CBS 102604 | T | Minneola tangelo | Israel | KP124334 | AY562410 | KP125110 |
| A. alternata | AA12 | Citrus reticulata “Nova” | Italy | KX056320 | KX019993 | KX064070 | |
| A. alternata | AA16 | Citrus sinensis “Tarocco Sciara” | Italy | KX056322 | KX020124 | KX064074 | |
| A. alternata | CBS 119399 | T | Minneola tangelo | USA | KP124361 | JQ646328 | KP125137 |
| A. alternata | CBS 119543 | T | Citrus paradisi | USA | KP124363 | KP124215 | KP125139 |
| A. alternata | CBS 127672 | T | Astragalus bisulcatus | USA | KP124382 | KP124234 | KP125160 |
| A. alternata | AR1 | Citrus sinensis | Italy | PP301467 | PP347722 | PQ273723 | |
| A. alternata | AR2 | Citrus sinensis | Italy | PP301468 | PP347723 | PQ273724 | |
| A. alternata | AR3 | Citrus sinensis | Italy | PQ008557 | PQ015599 | PQ273725 | |
| A. alternata | AR6 | Citrus sinensis | Italy | PP301469 | PP347724 | PQ273726 | |
| A. alternata | AR7 | Citrus sinensis | Italy | PP301470 | PP347725 | PQ273727 | |
| A. alternata | AR8 | Citrus sinensis | Italy | PP301471 | PP347726 | PQ273728 | |
| A. alternata | AR9 | Citrus sinensis | Italy | PP301472 | PP347727 | PQ273729 | |
| A. alternata | AR10 | Citrus sinensis | Italy | PP301473 | PP347728 | PQ273730 | |
| A. alternata | AR11 | Citrus sinensis | Italy | PP301474 | PP347729 | PQ273731 | |
| A. alternata | MN1 | Citrus reticulata cv. Nova | Italy | PP301475 | PP347730 | PQ273732 | |
| A. alternata | MN3 | Citrus reticulata cv. Nova | Italy | PP301476 | PP347731 | PQ273733 | |
| A. alternata | MN4 | Citrus reticulata cv. Nova | Italy | PP301477 | PP347732 | PQ273734 | |
| A. alternata | MN5 | Citrus reticulata cv. Nova | Italy | PP301478 | PP347733 | PQ273735 | |
| A. alternata | MN7 | Citrus reticulata cv. Nova | Italy | PP301479 | PP347734 | PQ273736 | |
| A. arborescens | CBS 102605 | T | Solanum lycopersicum | USA | AF347033 | AY278810 | KC584636 |
| A. arborescens | CBS 113.41 | Schizantus sp. | Unknown | KP124395 | KP124247 | KP125173 | |
| A. arborescens | CBS 108.41 | wood | Unknown | KP124394 | KP124246 | KP125172 | |
| A. arborescens | AA19 | Citrus sinensis | Italy | KX056400 | KX020111 | KX064213 | |
| A. arborescens | AA35 | Citrus sinensis | Italy | KX056330 | KX019995 | KX064214 | |
| A. betae-kenyensis | CBS 118810 | T | Beta vulgaris subsp. cicla | Kenya | KP124419 | KP124270 | KP125197 |
| A. burnsii | CBS 107.38 | T | Cuminum cyminum | India | NR_136119 | JQ646305 | KP125198 |
| A. eichhorniae | CBS 119778 | Eichhornia crassipes | Indonesia | KP124426 | KP124277 | KP125205 | |
| A. eichhorniae | CBS 489.92 | T | Eichhornia crassipes | India | KC146356 | KP124276 | KP125204 |
| A. gossypina | CBS 102601 | T | Minneola tangelo | Colombia | MH862801 | KP124282 | KP125212 |
| A. iridiaustralis | CBS 118486 | T | Iris sp. | Australia | NR_136120 | KP124284 | KP125214 |
| A. jacinthicola | CBS 133751 | T | Eichhornia crassipes | Mali | KP124438 | KP124287 | KP125217 |
| A. longipes | CBS 539.94 | Nicotiana tabacum | USA | KP124441 | KP124290 | KP125220 | |
| A. tomato | CBS 103.30 | Lycopersicon esculentum | Unknown | KP124445 | KP124294 | KP125224 | |
| Isolate | Phenotype | Average Mycelial Growth y | Sporulation Rate (%) y |
|---|---|---|---|
| A. alternata AA1 | (sensitive) | 7.1 ± 0.08 bc | 38.3 ± 5.3 a |
| A. alternata AA14 | (sensitive) | 5.8 ± 0.06 d | 4.9 ± 0.3 c |
| A. alternata AA36 | (sensitive) | 7.1 ± 0.04 bc | 30.2 ± 3.2 ab |
| A. alternata AA103 | (sensitive) | 7.0 ± 0.04 bc | 18.9 ± 1.8 b |
| A. alternata A107 | (sensitive) | 6.6 ± 0.05 c | 4.1 ± 0.2 c |
| A. alternata MN3 | (sensitive) | 7.4 ± 0.07 ab | 25.8 ± 3.9 b |
| A. alternata AA2 | (reduced sensitivity) | 7.4 ± 0.28 ab | 4.1 ± 0.1 c |
| A. alternata MN5 | (reduced sensitivity) | 7.8 ± 0.03 a | 3.6 ± 0.7 c |
Disclaimer/Publisher’s Note: The statements, opinions and data contained in all publications are solely those of the individual author(s) and contributor(s) and not of MDPI and/or the editor(s). MDPI and/or the editor(s) disclaim responsibility for any injury to people or property resulting from any ideas, methods, instructions or products referred to in the content. |
© 2024 by the authors. Licensee MDPI, Basel, Switzerland. This article is an open access article distributed under the terms and conditions of the Creative Commons Attribution (CC BY) license (https://creativecommons.org/licenses/by/4.0/).
Share and Cite
Leonardi, G.R.; Quatra, G.L.; Gusella, G.; Aiello, D.; Vitale, A.; Camiletti, B.X.; Polizzi, G. Sensitivity Profile to Pyraclostrobin and Fludioxonil of Alternaria alternata from Citrus in Italy. Agronomy 2024, 14, 2116. https://doi.org/10.3390/agronomy14092116
Leonardi GR, Quatra GL, Gusella G, Aiello D, Vitale A, Camiletti BX, Polizzi G. Sensitivity Profile to Pyraclostrobin and Fludioxonil of Alternaria alternata from Citrus in Italy. Agronomy. 2024; 14(9):2116. https://doi.org/10.3390/agronomy14092116
Chicago/Turabian StyleLeonardi, Giuseppa Rosaria, Greta La Quatra, Giorgio Gusella, Dalia Aiello, Alessandro Vitale, Boris Xavier Camiletti, and Giancarlo Polizzi. 2024. "Sensitivity Profile to Pyraclostrobin and Fludioxonil of Alternaria alternata from Citrus in Italy" Agronomy 14, no. 9: 2116. https://doi.org/10.3390/agronomy14092116
APA StyleLeonardi, G. R., Quatra, G. L., Gusella, G., Aiello, D., Vitale, A., Camiletti, B. X., & Polizzi, G. (2024). Sensitivity Profile to Pyraclostrobin and Fludioxonil of Alternaria alternata from Citrus in Italy. Agronomy, 14(9), 2116. https://doi.org/10.3390/agronomy14092116







